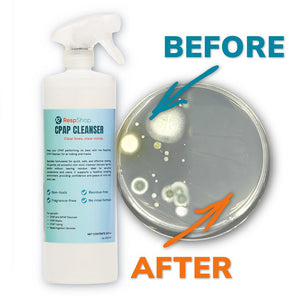
CPAP Mask & Tubing Cleanser & Deodorant | Powerful, Safe, and Non-Toxic (32oz)

Cleaning Supplies
Keep your CPAP equipment fresh and hygienic with essential cleaning supplies. This category includes mask wipes, disinfecting sprays, tube brushes, soap, and sanitizing devices designed to safely clean masks, tubing, water chambers, and other components. Regular cleaning helps extend the life of your equipment and supports healthy therapy.
Filter and sort
14 products
Shop by Category:
- Oxygen Concentrators (45)
- View All (45)
- Portable O2 Concentrators (9)
- Home Use O2 Concentrators (4)
- Oxygen Concentrator Accessories (17)
- Nasal Cannulas and Adapters (11)
- Sieve Beds (3)
- Power & Battery (14)
- Oximeter & Oximetry (4)
- Nebulizers (3)
- View All (3)
- Nebulizers (3)
- Nebulizer Supplies (10)
- Open Box & Refurbished (8)
- View All (8)
- Open Box Items (3)
- Refurbished Machines (5)
- Sleep Comfort (6)
- View All (6)
- Services (2)
- View All (2)
 CPAP Machines (11)
CPAP Machines (11)
 CPAP Masks & Parts (209)
CPAP Masks & Parts (209)
 CPAP Supplies (192)
CPAP Supplies (192)
 View More (45)
View More (45)
Filter by:
Compare products (0/5)
Compare products
HOW CAN WE HELP?
Not sure exactly what you need? Our therapy package bundles CPAP, CPAP Supplies, and support for a simple start. Or a Sleep Champion can help direct your shopping experience.